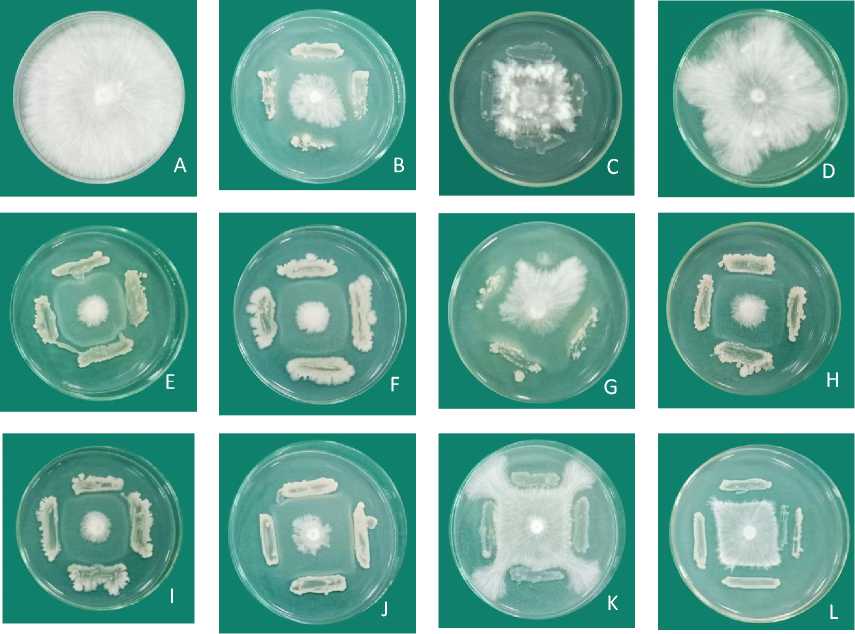

UJI EFEKTIVITAS RIZOBAKTERI SEBAGAIA GEN ANATGONIS Sclerotium rolfsii PENYEBAB PENYAKIT BUSUK BATANG PADA TANAMAN KACANG TANAH (Arachis hypogea L.)
on
J. Agric. Sci. and Biotechnol.
ISSN: 2302-0113
Vol. 8, No. 1, Juli 2019
UJI EFEKTIVITAS RIZOBAKTERI SEBAGAIA GEN ANATGONIS Sclerotium rolfsii PENYEBAB PENYAKIT BUSUK BATANG PADA TANAMAN KACANG TANAH (Arachis hypogea L.)
Ni Kadek Desy Andya Dewi1, Dewa Ngurah Suprapta2, dan Khamdan Khalimi2*)
-
1Program Magister Bioteknologi Pertanian, Program Pascasarjana Universitas Udayana
-
2Laboratorium Biopestisida Fakultas Pertanian Universitas Udayana *)Corresponding author: khamdankhalimi@yahoo.com
Abstract
Groundnut (Arachis hypogea L.) is one of important commodities in Indonesia, however the production of groundnut is still relatively low which is partly because of the plant disease i.e. stem rot disease caused by Sclerotium rolfsii. Rhizobacteria is one of the solutions to be used as the biological control agent against S. rolfsii. The aim of this study is to know the effectiveness of rhizobacteria to control stem rot disease caused by S. rolfsii. The results the study showed that among 130 isolates of rhizobacteria tested against S. rolfsii, 11 isolates showed inhibitory activity, and among them one isolate, BjTk11 from exposed the highest inhibitory activity (96.09%) against S. rolfsii. On a green house experiment, treatment with formula of isolate BjTk 11 at doses of 5 g, 10 g, 15 g and 20 g per polybag effectively controlled the pre emergence damping off (disease incidence = 0%) while the disease incidence on control was 23.5%. No post emergence damping off symptom was observed on groundnut treatment with formula of isolate BjTk11, while the disease incidence on control was 75%. The number of sclerotia in soil of control was 79/gram of soil which is obviously higher than those of treatments. The mode of action the rhizobacteria isolates BjTk11 in inhibiting the growth of S. rolfsii is through antibiosis where the rhizobacteria produce the antifungal compound Butanedial, R - (-) - 1,2-
propanediol, 2,3-Butanediol, Isopropyl Alcohol, Acetic acid, anhydride with formic Acid , 2-bromohexane, 4,5-Diamino-6-hydroxypyrimidine, 4H-Pyran-4-one, 3-hydroxy-2-methyl and Cyclotrisiloxane, hexamethyl-. The presence of these compounds probably closely related to the inhibitory activity against S. rolfsii.
Keyword s: Groundnut, stem rot disease, Sclerotium rolfsii, rhizobacteria
Kacang tanah (Aracis hypogea L.) adalah salah satu komoditas pertanian utama di Indonesia. Indonesia harus mengimpor sekitar 30% dari total permintaan kacang tanah, karena produksi dalam negeri tidak dapat memenuhi permintaan domestik. Berdasarkan data yang ditunjukkan oleh Badan Statistik Indonesia (2016), produksi kacang tanah pada tahun 2012 adalah 712.857 ton, turun menjadi 605.449 pada tahun 2015. Salah satu penyebabnya adalah terjadinya penyakit tanaman. Salah satu penyakit yang paling hancur adalah penyakit busuk batang yang disebabkan oleh Sclerotium rolfsii (Rani, 2017). Adiver (2003) melaporkan bahwa serangan S. rolfsii pada kacang tanah mengakibatkan 25-50% kehilangan hasil, yang akan sangat berbahaya bagi petani.
Pestisida kimia biasanya digunakan untuk mengendalikan penyakit busuk batang yang disebabkan oleh S. rolfsii. Penggunaan pestisida kimia buatan dapat membahayakan ekosistem karena akumulasi bahan kimia aktif yang sulit terurai oleh mikroorganisme.
Mengendalikan penyakit busuk batang yang disebabkan oleh S. rolfsii dapat dilakukan dengan menggunakan rizobakteria yang diklasifikasikan ke dalam Plant Growth Promoting Rhizobacteria (PGPR). Rizobakteria adalah bakteri yang hidup dan berkembang di sekitar tanaman yang dapat bermanfaat bagi tanaman. Ini bekerja dalam menyediakan nutrisi untuk tanaman dan mobilisasi nutrisi pada tanaman. Salah satu mekanisme rizobakteria dalam melindungi tanaman adalah menginduksi resistensi sistemik sehingga keberadaan infeksi pathogen dapat dihambat dan tidak mengganggu pertumbuhan tanaman. Resistensi sistemik yang diinduksi tergantung pada kolonisasi sistem root oleh rhizobacteria. Kolonisasi rhizobacteria dapat terjadi melalui stek benih atau penambahan suspensi rhizobacteria ke dalam tanah setelah transplantasi.
Rhizobakteria dapat ditemukan di rizosfer tanaman yang dikaitkan dengan akar tanaman yang bertindak sebagai bakteri antagonis seperti Bacillus spp., dan Pseudomonas fluorescens. Menurut Sumartini, rhizobacteria 2011 yang berasal dari risosfer tanaman kacang lebih efektif dalam mengendalikan jamur S. rolfsii sebagai penyebab busuk batang pada tanaman kacang tanah. Adapun tujuan dari penelitian ini adalah untuk mengetahui efektivitas dari rizobakteria dalam mengendalikan penyakit busuk batang yang disebabkan oleh jamur S. rolfsii pada kacang tanah.
Penelitian ini dilaksanakan di Laboratorium Biopestisida dan di Kebun Percobaan Fakultas Pertanian Universitas Udayana dari bulan Desember 2017 sampai dengan bulan Juni 2018.
-
2.2 PelaksanaanPenelitian
Isolat Rhizobacteria dan isolat S. rolfsii disediakan oleh Laboratorium Biopestisida Fakultas Pertanian Universitas Udayana. Uji in vitro dilakukan di Laboratorium Biopestisida, Fakultas Pertanian, Universitas Udayana, sedangkan uji in vivo dilakukan di rumah kaca Fakultas Pertanian, Universitas Udayana. Analisis molekuler 16S rRNA dilakukan di Genetika Science Indonesia, Jakarta, dan analisis senyawa antijamur dilakukan di Laboratorium Forensik POLDA Bali. Sebanyak 130 isolat rhizobacteria diuji aktivitas daya hambat terhadap S. rolfsii pada media PDA. Isolat dengan daya hambat tertinggi dipilih dan digunakan untuk pengujian lebih lanjut seperti identifikasi molekuler, uji efektivitas pada tanaman kacang tanah di rumah kaca, menganalisis senyawa antijamur menggunakan metode GC-MS. Data dianalisis secara statistic dengan ANOVA (Analysis of Varians). Apabila uji F menunjukkan pengaruh nyata, maka dilanjutkan dengan uji beda rata-rata Duncan’s Multiple Range Test (DMRT) taraf 5%.
Jamur S. rolfsii
Hasil penelitian menunjukkan bahwa di antara 130 isolat rizobakteri diuji terhadap S. rolfsii, 11 isolat menunjukkan adanya daya hambat terhadap jamur tersebut. Isolat tersebut adalah isolate BjTk11, Rend11, BjB11, MjSg79, MjSg25, BcBd33, MjSg21, BjOR4, BlBd14 dan MwBd19. Terdapat satu isolate yang memiliki daya hambat paling tinggi mencapai 96,09% terhadap S. rolfsii yaitu isolate BjTk11.
Table 1 Daya hambat rizobakteri terhadap jamur S. rolfsii
|
No. |
Isolat |
Diameter kolonijamurS.rolfsii(mm2) |
DayaHambat(%) |
|
1. |
BjTk11 |
200a*) |
96.09 |
|
2. |
Rend11 |
256.67ab |
94.98 |
|
3. |
BjBl1 |
271.33ab |
94.70 |
|
4. |
MwBd11 |
311.67bc |
93.91 |
|
5. |
MjSg79 |
346c |
93.24 |
|
6. |
MjSg25 |
712d |
86.08 |
|
7. |
BcBd33 |
1051e |
79.46 |
|
8. |
MjSg21 |
1520.33f |
70.28 |
|
9. |
BjOR4 |
2177.33g |
57.44 |
|
10. |
BlBd14 |
3928.33h |
23.21 |
|
11. |
MwBd19 |
4316.33i |
15.63 |
|
12. |
Control |
5116.0000j |
0 |
Keterangan: Nilai yang diikuti huruf sama pada masing-masing perlakuan pada kolom yang sama
menunjukkan tidak berbeda nyata berdasarkan uji DMRT 5%.
Menurut Fernando et al. (2005), mekanisme penghambatan tersebut adalah dengan menghasilkan antibiotik, toksin, siderofor, serta hidrogensianida (HCN. Kemampuan rizobakteri dalam menghasilkan senyawa antibiotic untuk menghambat pertumbuhan patogen juga telah dilaporkan beberapa peneliti. Reddy (2014) menyatakan bahwa spesies bakteri Pseudomonas spp. dan Bacillus spp. Mampu menekan pertumbuhan pathogen tanaman dengan memproduksi senyawa antibiotik yang bersifat antijamur. Sarvani dan Reddy (2013) menyatakan bahwa sebanyak 7 isolat bakteri Bacillus sp. mampu memproduksi siderofor dan hidrogensianida (HCN) ketika diuji kemampuan antagonisnya terhadap jamur S. rolfsii secara in vitro. Menurut Ramyasmruthi et al. (2012), enzimlitik yang dihasilkan mikroba mampu mendegradasi dinding sel jamur dengan cara memecah ikatan dari senyawa polimer, seperti: kitin, selulosa, hemiselulosa, dan protein.
Gambar 1. Aktivitas penghambatan beberapa rizobakteri terhadap pertumbuhan jamur S. rolfsii pada media PDA umur 3 hari setelah inokulasi. (A) Control (B) cultured with isolate MjSg25, (C) MjSg21, (D) MwBd19, (E) Rend11, (F) BjB11, (G) BlBd14, (H) BjTk11, (I) MwBd11, (J) MjSg79, (K) BjOr4, (L) BcBd33
-
a. Identifikasi molekuler Rizobakteri Isolat BjTk11
Amplifikasi PCR dengan menggunakan 16S rRNA dengan 16S primers (63F 5'-CAG GCC TAA CAC ATG CAA GTC-3 ' dan 1387R (5'-GGG CGG WGT GTA CAA GGC-3 ') dan panjang produk DNA adalah ± 1,300 pb (Gambar 2).
1.300 pb -----
3000 bp
1,500 bp
1.000 bp
Gambar 2. Hasil PCR dari rizobakteri isolat BjTk11
Hasil analisis pohon pilogeni dengan menggunakan metode Maximum Parsimony (MP) dengan 1,000 kali ulangan menunjukan bahwa rizobakteri isolat BjTk11 adalah Bacillus velezensis, (Gambar 3). Dharmayanti (2011) menyatakan bahwa untuk cabang dalam topologi filogenetik dapat diprediksi signifikan jika set data yang di-resampled harus diulang (misalnya> 70%) dalam memprediksi cabang yang sama.
— MH211277 1 Bacillus Velezensis strain PgBe186 — MH211274 1 Bacillus velezensis strain PgBe183 — MH211270 1 Bacillusvelezensisstrain PgBe179 — MH211265 1 Bacillusvelezensis strain PgBe174 — MH211243 1 Bacillusvelezensisstrain PgBe151 ιoo —MH174291 1 BacillusvelezensisstrainWU 3
— MH166800 1 Bacillus velezensis strain WU 2
— MH165951 1 BacillusvelezensisstrainWUO
— MH134486 1 Bacillus velezensis strain JTYP2
— MH000677 1 Bacillus velezensis strain T49
— MG813969 1 Bacillus velezensis strain MML5745
-
l- Isolat BJTK11
100
- NFDV01000190 1 Bacillus thuringie∩sis serovar aizawai strain BGSC 4J2
-
1— NZ MOOO01000156 1 Bacillus thuringiensis serovar argentinensis strain BGSC — AY353301 1 Salmonella enterica strain CDC str 941 phase 2 Aagellin AjB gene
llllllllllllllll∣l∣ll 0.0 1000
Gambar 3. Analsisi Filogeni dari isolat BjTk11
-
3.3 Uji efektivitas formula rizobakteri isolat BjTk11 untuk mengendalikan Penyakit Busuk Batang pada Kacang Tanah di RumahKaca
Pada percobaan rumah kaca, perlakuan dengan formula isolate BjTk 11 dengan dosis 5 g, 10 g, 15 g dan 20 g per polybag secara efektif mengendalikan
redaman kemunculan pra-kejadian (insiden penyakit = 0%) sementara insiden penyakit pada control adalah 23,5%. Tidak ada gejala kemunduran pasca kemunculan yang diamati pada perlakuan kacang tanah dengan formula isolat BjTk11, sedangkan kejadian penyakit pada control adalah 75%.
|
Dosis (gram/tanaman) |
Pre-emergencerebahkecambah (%) |
Post emergencerebahkecambah (%) |
|
0 (K+) |
32.25 a |
80 a |
|
0 (K-) |
0 b |
0 b |
|
5 |
0 b |
0 b |
|
10 |
0 b |
0 b |
|
15 |
0 b |
0 b |
|
20 |
0 b |
0 b |
Cara kerja rhizobacteria mengisolasi BjTk11 dalam menghambat pertumbuhan S. rolfsii adalah melalui antibiotik di mana rizobakteria isolate BjTk11 setelah dianalisis dengan GC-MS menghasilkan senyawa antijamur Butanedial, R - (-) - 1,2-propanediol, 2,3-Butanediol, Isopropyl Alkohol, Acetic asam, anhidrida dengan Asam format, 2-bromoheksana, 4,5-Diamino-6-hidroksifrimidin, 4H-Pyran-4-one, 3-hidroksi-2-metil dan Sikotrisiloksan, hexamethyl-. Kehadiran senyawa-senyawa ini mungkin terkait erat dengan aktivitas penghambatan terhadap S. rolfsii.
-
4.1 Kesimpulan
Berdasarkan penelitian tersebut dapat disimpulkan bahwa:
-
1. Isolat Rhizobacteria BjTk11 secara efektif menghambat pertumbuhan Sclerotium rolfsii penyebab penyakit busuk batang pada kacang tanah dengan aktivitas penghambatan sebesar 96,09% pada media PDA.
-
2. Formula BjTk11 dengan dosis 5 hingga 20 gram per pot, secara efektif menekan gejala penyakit akar batang pada kacang tanah.
-
3. Isolate BjTk11 diidentifikasisebagaiBacillus velezensis
-
4. Mekanisme isolat rhizobacteria BjTk11 dalam menghambat pertumbuhan S. rolfsii adalah melalui antibiotic dengan memproduksi senyawa antijamur seperti Butanedial, R - (-) - 1,2-propanediol, 2,3-Butanediol, Isopropyl Alkohol, Acetic asam, anhidrida dengan Asam format, 2-bromoheksana, 4,5-Diamino-6-hydroxypyrimidine, 4H-Pyran-4-one, 3-hydroxy-2-methyl dan Cyclotrisiloxane, hexamethyl.
-
4.2 Saran
Adapun saran dalam penelitian ini adalah perlu dilakukan uji lapangan perlu dilakukan untuk mengetahui efektivitas formula isolat BjTk11 untuk mengendalika npenyakit busuk batang pada kacang tanah dalam kondisi lapangan.
Daftar Pustaka
Adiver S.S. 2003. Influence of Organic Amendments and Biological Components on Stem Rot of Groundnut. National Seminar on Stress Management inOilseeds For Attaining Self Reliance in Vegetable Oil Indian Society of OilseedsResearch, Directorate of OilseedsResearch, Hyderabad. January 28 -30, pp. 15-17.
Ramamoorthy, V., Raguchander, T. and Samiyappan, R. 2002. Induction of defence related proteins in tomato roots treated with Pseudomonas fluorescens Pf1 and Fusarium oxysporum f.sp. lycopersici. Plant and Soil. 239, 55-68
Rani, R. A. 2017. STEM ROT OF GROUNDNUT INCITED BY SCLEROTIUMROLFSII SACC. AND IT’S MANAGEMENT - A REVIEW. International Journal of AgriculturalScience and Research . 7: 327-338
United Stade Department of Agriculture Natural Resources Conservation https://plants.usda.gov/java/ClassificationServlet?source=profile&symbol =ARHY&display=31
USDA-FAS. 2010. United States Department of agricultural service groundnut area, yield, and production.
[http://www.fas.usda.gov/psdonline/psdQuery.aspx] date of accessed on June, 22nd 2018
Reddy, P.P. 2014. Plant Growth Promoting Rhizobacteria for Horticultural Crop Protection. India: Springer.
Sarvani, B. and Reddy, R.S. 2013. In vitro Screening of Native Bacillus Isolates for Plant Growth Promoting Attributes. International Journal of Bioresource and Stress Management. 4 (2): 298-303.
https://ojs.unud.ac.id/index.php/JASB
7
Discussion and feedback